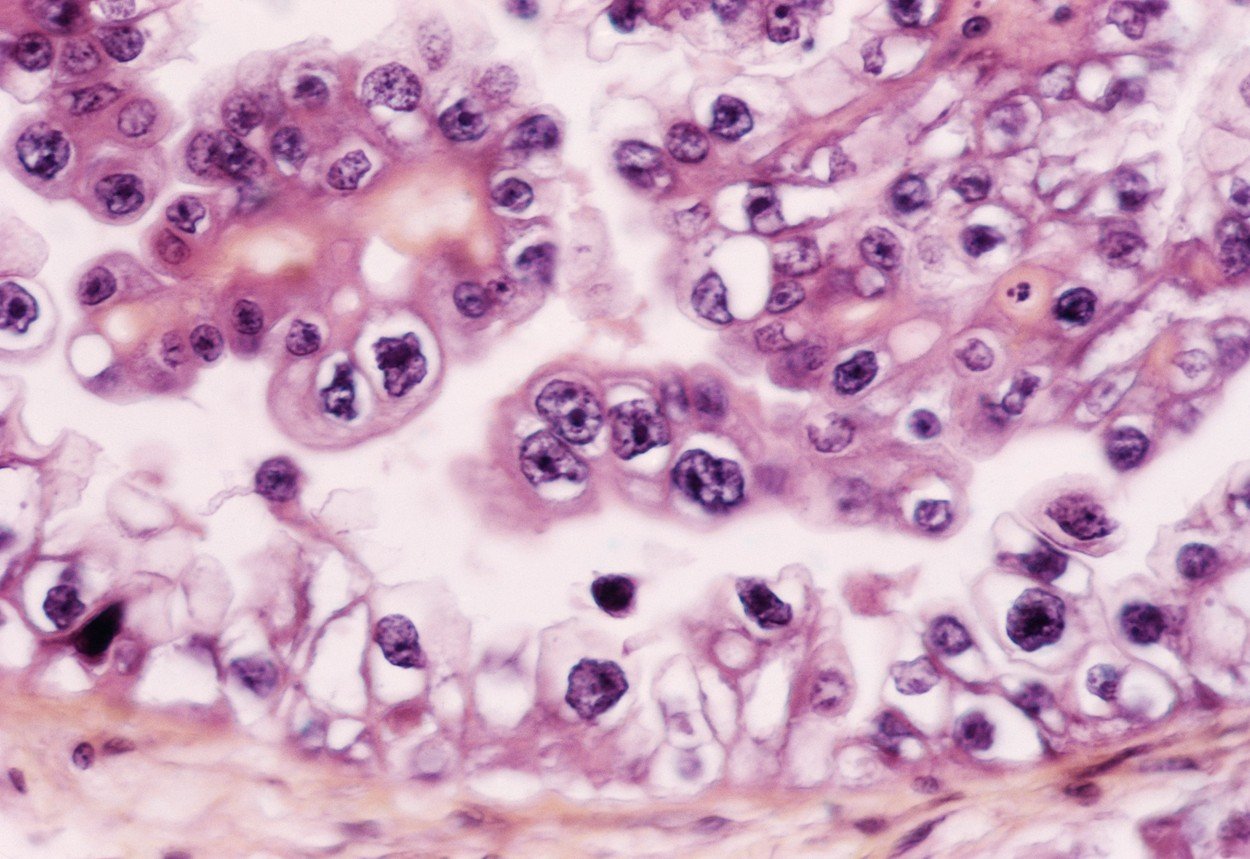
profimedia-0102420325

Krvna pretraga za 10 različitih vrsta raka mogla bi jednog dana pomagati liječnicima da utvrde bolest prije nego što pacijenti pokažu simptome, piše Guardian.
Naime, pretraga pod nazivom likvidna biopsija detektira sićušne dijelove DNK koje u krv ispuštaju stanice raka. Naročito dobre rezultate pretraga daje u slučaju raka jajnika i gušterače, iako se radi o malom broju detektiranih rakova do sada (putem ove metode ukupno je utvrđeno tek 10 slučajeva raka jajnika, iako je čak 90% pouzdan način).
Istraživači se nadaju da će ovakvo testiranje postati dio univerzalne pretrage koju liječnici mogu koristiti za otkrivanje raka kod pacijenata.
"Ovo je mogući sveti gral istraživanja raka, pronaći teško izlječive vrste raka u ranijem stadiju kada ih je lakše liječiti. Nadamo se ...

Za sudjelovanje u komentarima je potrebna prijava, odnosno registracija ako još nemaš korisnički profil....